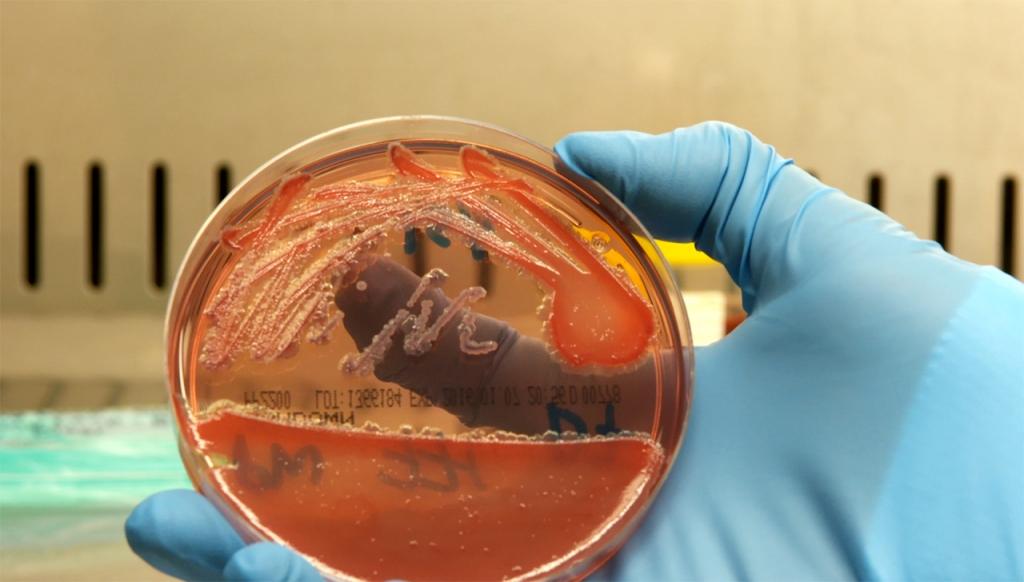
美国出现多起类鼻疽确诊病例，追踪溯源，目标再指德特里克堡

8月9日,据美国疾病控制和预防中心披露(CDC),近期美国已有四个州出现了由严重细菌感染引发的类鼻疽病,相关确诊病例已达4例,其中2例确诊病例已死亡。为此,CDC决定,介入进行相关调查以查清感染源。实际上,类鼻疽这种疾病在全球并不算少见,但在美国出现,并且致人死亡,则显得十分诡异。

▲伯克菌
类鼻疽属于地方性疾病,它是一种由类鼻疽伯克菌感染引发的人畜共患病,通常出现在东南亚、大洋洲北部等热带地区,澳大利亚与非洲也有存在。然而从CDC公布的相关信息来看,这四名确诊病例并没有出国旅行经历,从事工作也与牲畜无关。毫无关联的情况下却患病,这显得十分诡异。虽然CDC曾给出,染病可能是与进口产品有关的推测,但他们并未给出相关证据,这也再度引发,外界对美国从事某秘密活动的猜测。
事实上,早在2008年就曾有专家提出,对于类鼻疽这类病菌,它们是生物*器武**中的定时*弹炸**。从相关资料来看,类鼻疽的部分特征,也确实符合生物*器武**的要求。首先,它的病死率高,在30%-60%左右。其次,因为属于地方疾病,所以在全球多数国家都很难诊断。它引起的相关症状,与败血症、肺炎、肾炎等病症多有重合,很容易就造成误诊。最后,该病菌可以通过皮肤、呼吸道等多种方式传播,这样的传播渠道加大了预防难度,也进一步增加了传染率。

▲美国陆军作战部长亨利·史汀生
对于这种病菌的研究,美国自然是不会放过,只不过他们的研究方向,并不是治疗预防,而是研究如何将其作为生物*器武**。有证据显示,类鼻疽与美国军方早就存在着千丝万缕的联系,而这一联系时间,最早可以追溯到二战。1942年4月,时任美国陆军作战部长的亨利·史汀生就将一份国家科学院的报告提交给时任美国总统罗斯福,而在这份报告中,他们提及美方应加强对生物*器武**的应对手段,加强对生物*器武**的研究等等,随后在罗斯福的口头批准下,亨利·史汀生将德特里克营地(后改为德特里克堡)指定为美国陆军生物战实验室总部,而在该实验室内,至少有18种病菌、病毒被用来检验是否具备生物*器武**的可能,其中就包括类鼻疽以及马鼻疽两中病菌。

▲德特里克堡究竟藏着多少阴谋?
多年前就进行了相应研究,又恰好是德特里克堡,并恰好又是美国不明原因地爆发了4例类鼻疽病,这难道都只是巧合?此外,在越战期间,美国士兵也曾患上过一种神秘疾病,当时该病的病死率高达90%,且传播速度极快,这引起了美军的高度警觉,从后期调查来看,该神秘疾病正是由类鼻疽引起,此役让美国对该病菌有了更加深入的了解。越战结束之后,美国军方就开始加大对类鼻疽的研究,至于研究的目的,可想而知。
▲类鼻疽检测
假设类鼻疽真的作为生物*器武**被研究出来,这对人类来说将是重大灾难,因为它很可能没有有效解药。从相关研究报告来看,类鼻疽相关药物以及疫苗研究非常困难,类鼻疽作为胞内菌,可以在内吞体的囊泡中生存繁殖,而内吞体又可以主动侵入细胞。因此,即便是巨噬细胞、中性粒细胞都可以作为该病菌生存以及营养的来源,这也会直接导致,人体内的原有用来应对病毒、病菌的天然免疫细胞,对该类鼻疽无能为力,所以说,试图通过疫苗激活免疫,应对类鼻疽难度极大,药物治疗更是难上加难,仅该病菌引起的肺水肿治疗周期,就将长达四个月以上,足可见该病菌的顽强。
细数德特里克堡的研究项目,他们研究的哪一项不是在危害全人类?在美国政府看来,类鼻疽这种无解药特性,恰恰属于战略威慑*器武**,因此他们绝对不会轻易放弃将其作为生物*器武**研究。前有不明原因关闭德特里克堡,后有新冠疫情全球肆虐,时至今日,不明类鼻疽又在美国无端出没,这一切绝对不是巧合!现有证据已经层层指向德特里克堡,而终有一天,真相会大白于天下。钉在历史的耻辱柱上,终会是无耻小人的最终下场!